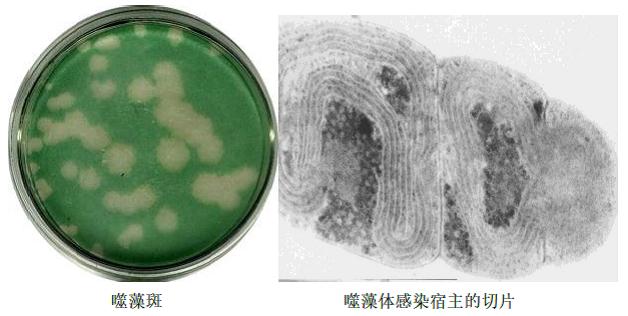

程凯,教授,博士,博士生导师 中国环境科学学会水环境分会常务理事 湖北工业大学南湖学者学术带头人 湖北工业大学环境微生物生态方向PI 荷兰国立生态研究所(NIOO)访问学者 |
|
|
|
|
截至2024年6月,主持国家科技重大项目课题、国家科技重大专项“水专项”子课题、国家重点研发计划子课题,国家自然科学基金项目、湖北省自然科学基金重点项目、武汉市科技攻关计划项目等纵向科研项目总经费800余万元,发表学术论文100余篇(其中SCI/EI论文二十余篇),授权发明专利7项,第一完成人成果鉴定1项,获得中国环境科学学会青年科技奖、教育部成果奖、中国光谷3551国际创业大赛全球总决赛二等奖、优秀硕士生导师等荣誉,担任湖北省经信厅委派的科技副总;所开发的“土著氨氧化菌剂脱氨增效技术”入选《武汉市水污染防治先进适用技术指导目录》;主授《环境生物学》、《高级水生生物学》、《生态工程》等课程,获得湖北工业大学青年教师授课竞赛优胜奖,多次指导学生获省科研成果奖、优秀毕业论文等。
主要从事水环境微生物相关的基础研究与应用开发:1、水体中病毒(噬藻体、浮游病毒等)的生态学基础研究;2、环境微生物技术应用开发(用微生物改善水环境质量的生物增效技术、环境微生物监测技术等)。
本科生主授专业:水务工程。
研究生招生专业:环境工程、资源循环利用工程、土木水利、土木工程。
主持的国家级科研项目
项目名称 |
编号 |
项目来源 |
经费(万元) |
全流域污染源、入湖污染负荷与社会经济现状调查与解析 |
2009ZX07105-001-01 |
国家科技重大专项子课题 |
345 |
污水微生物浓缩技术开发与装备研制 |
2024A01007-01 |
国家重大科技项目课题 |
300 |
闭闸期坝前缓流区土著生物增效技术集成 |
2017ZX07602002 |
国家科技重大专项课题专题 |
81 |
风光混合动力自主巡航清漂及垂向扰动控藻技术与装置 |
2016YFC0401702-03 |
国家重点研发计划项目子课题 |
78 |
二氧化碳浓度升高对浮游藻类病毒增殖及光修复能力的影响 |
31200385 |
国家自然科学基金 |
21 |
在国内率先开展了蓝藻病毒(噬藻体)的研究工作,作为主要完成人,报道了我国首株噬藻体(蓝藻病毒)的分离与鉴定,开展了该噬藻体在我国的空间分布、遗传多样性及感染力等方面的研究,发现该类噬藻体在富营养化水体中广泛分布,发表相关论文十余篇。
研究了全球变化对噬藻体(Cyanophage)生态功能的影响,论文发表于Frontiers in Microbiology (SCI 2区),并在美国西雅图举办的国际微生物生态学会(ISME13)、第七届亚洲太平洋藻类学论坛( APPF 2014 )及世界水科学年会2021(ASLO2021)做口头报告。
成功采用50吨发酵罐发酵生产放线菌AN02溶藻制剂,该制剂生态安全,
控藻性能高效稳定,在滇池现场的控藻效率高达90%,控藻时间超过30天。
所开发的《土著氨氧化菌剂脱氨增效技术》产业化效果显著,
已入选《2019年武汉市水污染防治先进适用技术指导目录》。
代表性论文
1. Cheng K(1/通讯作者), Cyanophage Propagation in the Freshwater Cyanobacterium Phormidium is Constrained by Phosphorus Limitation and Enhanced by Elevated pCO2. Frontiers in Microbiology 2019, 10:617. doi: 10.3389/fmicb.2019.00617
2. Cheng K(1/通讯作者), Combined effects of elevated pCO2 and warming facilitate cyanophage infections. Frontiers in Microbiology, 2017, 8:1096. doi: 10.3389/fmicb.2017.01096
3. Cheng Kai(1), An ecological study on dynamics of toxic microcystis blooms in a eutrophic park pond, Wuhan,China.Progress in natural science,2002,12(1):30-35
4. Cheng Kai(通讯作者),A novel freshwater cyanophage with a complex collar infects Limnothrix planktonica,Phycologia,2015,54 (6),578–582
5. Kai Cheng(通讯作者), The first isolation of a cyanophage-synechococcus system from the East China Sea, Virologica Sinica, 2013, 28 (5): 260-265
6. Cheng Kai(1), Solar radiation-driven decay of cyanophage infectivity, and photoreactivation of the cyanophage by host cyanobacteria, Aquatic Microbial Ecology,2007,48(1):13-18
7. Kai Cheng(通讯作者), Phytotoxic effects of cyanobacteria extract on Lemna minor and Myriophyllum spicatum:phyto-tolerance and superoxide dismutase activity, Environmental toxicology,2009,24(3):304-308
8. Cheng Kai (1), Temporal and spatial distribution of virioplankton in large shallow freshwater lakes, Chinese Journal of Oceanology and Limnology,2010,28(4):868-873
9. Kai Cheng(通讯作者), The effect of elevated carbon dioxide concentration on cyanophage PP multiplication and photoreactivation induced by a wild host cyanobacterium, Acta Ecologica Sinica, 2015, 35: 11–15
10. Kai Cheng(通讯作者),Characters of a Nitrobacter enrichment culture from a freshwater aquaculture pond, Biotechnology & Biotechnological Equipment, 2021, 35(1): 1343-1352
11. 程凯(2),我国首株噬藻体(蓝藻病毒)的分离与鉴定,自然科学进展,2002,12(9):923-927
12. 程凯(通讯作者),2株高效溶赤潮异湾藻放线菌的鉴定及溶藻特性,中国环境科学,2011,31(1):111-115
13. 程凯(通讯作者),pH 值及黏土密度对壳聚糖改性絮凝剂除藻效果的影响,中国环境科学,2015,35(5):1520-1525
14. 程凯(通讯作者),不同碳源对Delftia tsuruhatensis HT01脱氮性能的影响,中国环境科学,2019,39(4):1478-1484
15. 程凯(通讯作者),一株高适应性Nitrosomonas eutropha CZ-4的脱氨特性,中国环境科学,2019,39(8):3365~3372
16. 程凯(通讯作者),N. europaea/Nc. mobilis 谱系在实际垃圾渗滤液处理系统中的脱氨贡献,中国环境科学,2021,41(6):2602~2609
17. 程凯(通讯作者),高温和高盐对Nitrosomonas eutropha CZ-4的交叉保护效应,中国环境科学,2023,43(3):1378~1385
18. 程凯(通讯作者),铜绿微囊藻对自养氨氧化细菌的抑制作用,中国环境科学,2024,10.19674/j.cnki.issn1000-6923.20240621.002
19. 程凯(通讯作者),淡水湿地浮游病毒的空间分布,生态学报,2009,29(2):1048-1054
20. 程凯(通讯作者),不同光、温条件下野生宿主对噬藻体PP的光修复率,生态学报,2010,30(7):1868-1874
21. 程凯(通讯作者),CO2浓度和温度升高对噬藻体PP增殖的联合作用,生态学报,2012,32(22):6917-6924
22. 程凯(通讯作者),温度与CO2浓度升高对集胞藻PCC 6803修复UV损伤的关键基因转录量的影响,生态学报,2015,35(9),3132-3137
23. 程凯(通讯作者),一株海洋牟勒氏角毛藻(Chaetoceros muelleri)病毒的分离与初步鉴定,海洋与湖沼,2011,42(3):455-459
24. 程凯(1),浮游病毒的测定方法及其应用,水生生物学报, 2003,27(5):535-538
25. 程凯(通讯作者),营养条件对噬藻体PP感染席藻的动力学的影响,应用生态学报,2016,27(4):1271-1276
26. 程凯(1),感染丝状蓝藻的噬藻体的裂解周期和释放量的测定,中国病毒学 2002,17(4):374-376
27. 程凯(通讯作者),较高的代表性排放路径等级能提高噬藻体的感染力,湖泊科学,2023,35(4):1212-1221
28. 程凯(通讯作者),氨氮对3种吸附态亚硝化单胞菌的抑制动力学,微生物学通报,2021,48(11):3996-4005
29. 程凯(通讯作者),低功率密度超声波强化絮凝沉降除藻技术研究,水生态学杂志,2019,40(2):88-93
30. 程凯(通讯作者),一株嗜热嗜盐亚硝化单胞菌的氨氧化活性,环境科学与技术,2023,46(3):1-8
授权发明专利
1. 分泌胞外物质溶藻的溶藻微生物的高通量筛选方法ZL 201510503381.X
2. 亚硝酸菌的高通量筛选方法 ZL 201510503292.5
3. 一株耐高温亚硝化单胞菌及其在污水处理中的应用 ZL202011349440.X
4. 一株高适应性亚硝化单胞菌及其在污水处理中的应用 ZL201811529529.7
5. 一种缓解高盐对亚硝化单胞菌氨氧化活性抑制效应的方法 ZL202111554455.4
获奖